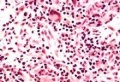
Bkmae.jpg

未使用文件
来自医学百科
下面为未被任何页面使用的文件。请注意,其他网站可能会通过URL直接链接某个文件,因此列表中的文件有可能仍在使用。
下面显示区间#1,801至#1,850的50条结果。
查看(前50个 | 后50个)(20 | 50 | 100 | 250 | 500)
- Gxpzc6c2.jpg 553 × 223;25 KB
- Gq0p0zen.jpg 341 × 237;9 KB
- Gks4i2ow.jpg 331 × 257;12 KB
- Bk0vo.jpg 400 × 278;64 KB
- Bkjvc.jpg 400 × 329;17 KB
- Gxpq040u.jpg 290 × 212;7 KB
- Gq0q42ro.jpg 477 × 415;27 KB
- 22.jpg 172 × 118;27 KB
- Bk005.jpg 200 × 200;12 KB
- Bkbns.jpg 150 × 246;7 KB
- Bk2e8.jpg 600 × 500;22 KB
- Bkmae.jpg 220 × 150;13 KB
- Bk6ll.jpg 300 × 301;94 KB
- Gq0od4tp.jpg 442 × 407;21 KB
- Bkjoo.jpg 348 × 348;25 KB
- Bk59e.jpg 869 × 423;19 KB
- Bk96r.jpg 242 × 300;18 KB
- Bk1s6.jpg 137 × 82;3 KB
- Bkkgh.jpg 139 × 127;5 KB
- Bk1cw.jpg 414 × 284;36 KB
- Bk9ub.jpg 137 × 200;16 KB
- Guwgmvrz.jpg 474 × 284;24 KB
- Bk4im.jpg 640 × 400;104 KB
- 70568363.jpg 500 × 366;59 KB
- Bkdp4.jpg 315 × 472;73 KB
- Bk037.jpg 400 × 300;86 KB
- Bk9zu.jpg 1,024 × 768;448 KB
- Bkjhc.jpg 500 × 454;54 KB
- Guwgh82c.jpg 284 × 328;9 KB
- Guwcg74w.jpg 504 × 307;24 KB
- Bknpy.jpg 140 × 109;4 KB
- Bk2bo.jpg 200 × 200;7 KB
- Bk1b5.jpg 800 × 531;64 KB
- Gxps902o.jpg 380 × 378;13 KB
- Bk34b.jpg 300 × 199;9 KB
- Bk15b.jpg 500 × 375;63 KB
- Bk4r6.jpg 367 × 229;15 KB
- Bk526.jpg 216 × 422;14 KB
- Bk0xx.jpg 279 × 224;14 KB
- Bk3n8.jpg 282 × 171;12 KB
- Gunprx8a.jpg 233 × 294;36 KB
- Gkrtauar.jpg 204 × 191;8 KB
- Bk1y9.jpg 677 × 567;29 KB
- Bk3ss.jpg 430 × 312;84 KB
- Bk537.jpg 120 × 131;4 KB
- Gum5q8px.jpg 569 × 182;12 KB
- Bknog.jpg 302 × 359;22 KB
- Bk1cz.jpg 490 × 735;54 KB
- Bk20l.jpg 472 × 365;24 KB
- Bklnq.jpg 500 × 392;56 KB